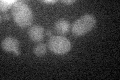
YKL176C
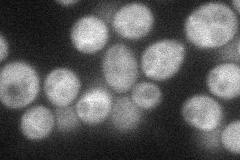
YKL176C
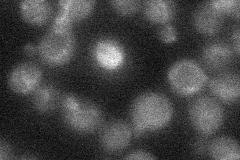
YKL176C
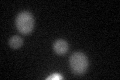
YKL176C
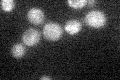
YKL176C
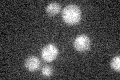
YKL176C

View description
Protein possibly involved in a post-Golgi secretory pathway; required for the transport of nitrogen-regulated amino acid permease Gap1p from the Golgi to the cell surface
Localization:
Intensity:
Fold change:
Significance:
-
C’ GFP library in SD
below threshold18.45 -
N' NOP1pr-GFP in SD
cytosol33.7622 -
N' TEF2pr-mCherry in SD

cytosol17.1216 -
N' NATIVEpr-GFP in SD
below threshold14.6746 -
N' TEF2pr-VC and Cyto-VN in SD

below threshold26.6941 -
C’ GFP library in SD+DTT
cytosol15.720.85No -
C’ GFP library in SD+H2O2
cytosol16.760.9No -
C’ GFP library in Starvation Media
cytosol19.91.07No -
C’ GFP library on the background of Pup2-DaMP

below threshold -
C’ GFP library on the background of CCT mutant

below threshold15.75740.853696No
